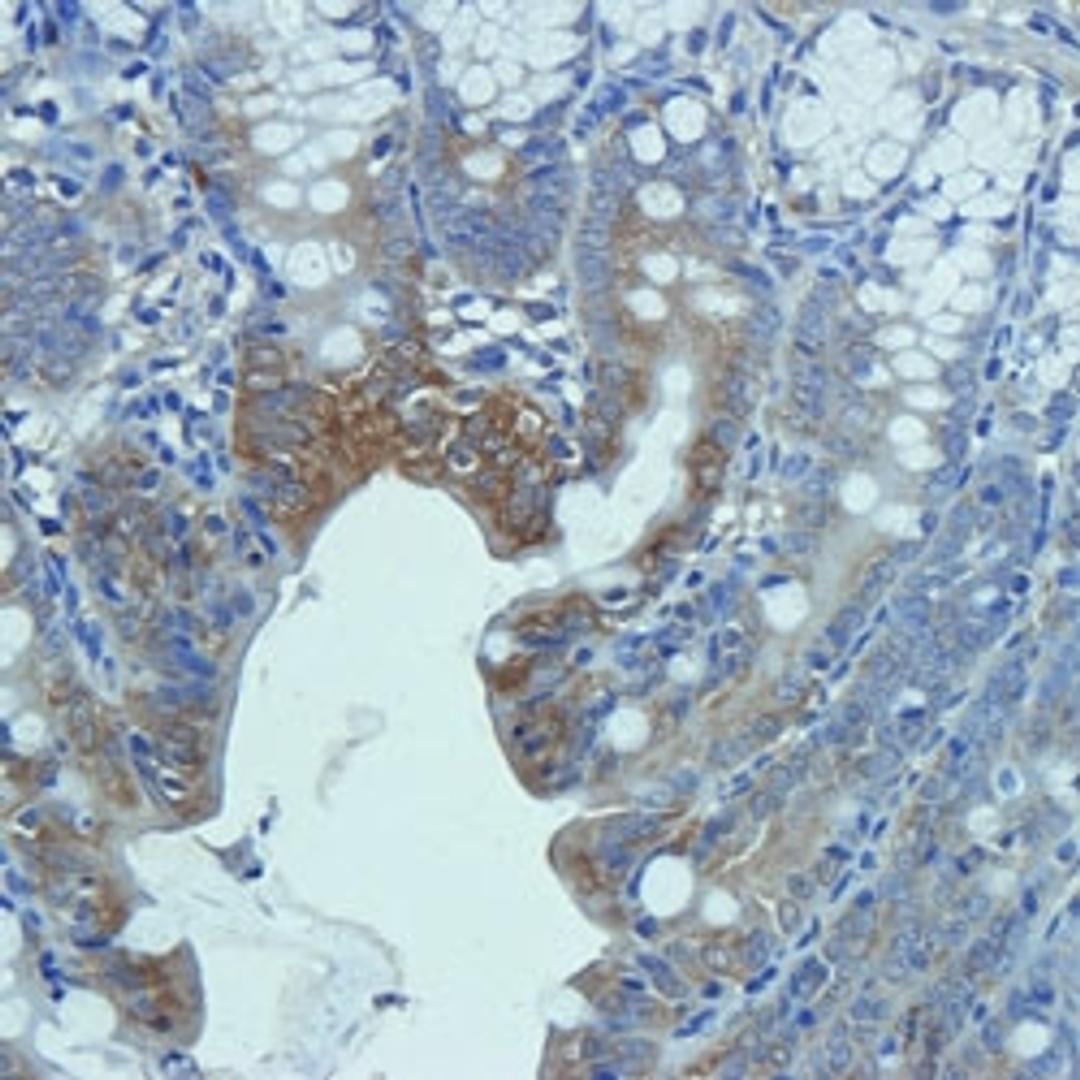
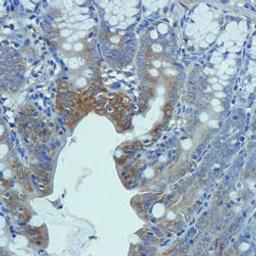

CD206 antibody
Rabbit polyclonal antibody to CD206.

The supplier does not provide quotations for this product through SelectScience. You can search for similar products in our Product Directory.
Willing to buy again.
Flow cytometry
High quality product with clear and reproducible results.
Review Date: 23 Jun 2020 | Biorbyt
Really good results for great value.
Western blot
Very easy to use and unbeatable price for quality of product.
Review Date: 23 Oct 2019 | Biorbyt
Great value for the money.
Analyze metabolite in purified tissue
The antibodies worked really well and have great reproducibility. Great value for the cost.
Review Date: 27 Jun 2019 | Biorbyt
Rabbit polyclonal antibody to CD206.
- Clonality Polyclonal
- Host Rabbit
- Reactivity Human, Mouse, Pig (Swine), Rat
- Conjugate Unconjugated
- Istotype IgG
- Gene 4360
- Quantity 100µg
- Format NULL
- Storage Store at 4°C for up to two weeks. For long term storage; aliquot and store at -20°C; avoid freeze/thaw cycles.
- Buffer 10 mM PBS; 0.02% sodium azide
Applications: ELISA (ELISA), Immunohistochemistry (Paraffin-Embedded Sections) (IHC (P))